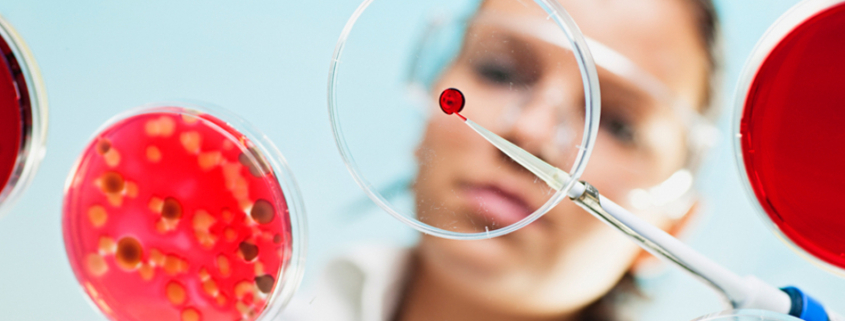

Bio-Recycling von Kunststoff: Mikroben machen aus Plastik neue Wertstoffe
Es gibt verschiedene Methoden, gebrauchtes Plastik sinnvoll zu verwerten. Ein weiterer Ansatz ist der Einsatz von Mikroben, Pilzen und Enzymen: Sie bauen Kunststoff nicht nur ab, sondern verwandeln ihn in nützliche Produkte – bis hin zu Medikamenten. Kunststoff ist eines der wichtigsten Materialien unserer Zeit – und dank seiner Recyclingfähigkeit ein zentraler Bestandteil der Kreislaufwirtschaft. Nun eröffnet sich ein neuer Ansatz: Das aus dem Abbau organischer Abfälle bekannte Bio-Recycling lässt sich auch auf Kunststoff anwenden. Es könnte herkömmliche Recyclingmethoden ergänzen und dazu beitragen, in die Umwelt gelangte Plastikabfälle gezielt abzubauen.
Die Bio-Recycler der Zukunft?
Es wurden Turbo-Enzyme, Power-Pilze und Super-Bakterien entdeckt, die Kunststoffe zersetzen. Ein Beispiel ist „Ideonella sakaiensis“, ein Bakterium, das PET mit Hilfe der Enzyme PETase und MHETase in seine Grundbausteine zerlegt[1]. Durch gezielte Auswahl und Optimierung geeigneter Enzyme lassen sich Varianten einsetzen, die den Plastikabbau deutlich beschleunigen. Auch Pilze wie „Parengyodontium album“ oder Bakterien namens „Pseudomonas stutzeri“ zeigen beeindruckende Abbauleistungen – selbst bei bislang schwer recycelbaren Kunststoffarten[2]. Die Befunde verdeutlichen: Bio-Recycling ermöglicht die effiziente Verwertung von Plastikabfällen und könnte zu einer wichtigen ergänzenden Strategie im Umgang mit Kunststoff werden.
Ein besonders bemerkenswerter Ansatz stammt von Forschern der University of Edinburgh. Sie entwickelten gentechnisch veränderte E.coli-Bakterien, die PET in Paracetamol, ein alltägliches Schmerz- und Fiebermittel, umwandeln können[3]. Der gesamte Prozess erfolgt bei Raumtemperatur und erzeugt nahezu keine CO₂-Emissionen – eine umweltfreundliche Alternative zur herkömmlichen Paracetamol-Produktion. Solche Beispiele zeigen, dass sich Plastik nicht nur abbauen, sondern auch in wertvolle Rohstoffe transformieren lässt – sauber, nachhaltig und innovativ. Selbst neue mikrobielle Gemeinschaften können sich durch Plastik entwickeln.
Wenn Plastik zur Bio-Plattform wird
Auf den Oberflächen von Kunststoffpartikeln entstehen sogenannte „Plastisphären“ – winzige, vom Menschen geschaffene mikrobielle Lebensräume. Hier siedeln sich Bakterien, Pilze und sogar kleine Krebstiere an. Mikroben bilden komplexe Strukturen und entwickeln Stoffwechselprozesse, um Plastik gezielt abzubauen. Gleichzeitig schaffen die Partikel für Insekten und Kleintiere neue Habitate in bisher unbewohnbaren Bereichen der Meere[4].
Plastisphären eröffnen Einblicke in Verwertungsprozesse und deren Potenzial für industrielles Recycling. Nicht nur im Meer. Beispielsweise sucht das führende Schweizer Forschungsinstitut für terrestrische Umweltsysteme WSL in kalten Regionen wie den Alpen und der Arktis nach Bakterien und Pilzen, die Plastik abbauen können. Entdeckt wurde eine überraschend große Vielfalt an Mikroorganismen, die ebenfalls an den Oberflächen von Kunststoffen leben. Dabei neu gefundene, kälteangepasste Bakterien und Pilze können biologisch abbaubare Kunststoffe schon bei 15 °C verdauen – deutlich unter den üblichen Zersetzungstemperaturen von 30 °C, was weniger Energie verbraucht[5].
Vom Plastikmüll zur wertvollen Ressource
Auch Projekte wie das EU-geförderte Recover-Projekt kombinieren Mikroorganismen, Enzyme, Regenwürmer und Insekten, um Plastik nicht nur abzubauen, sondern in wertvolle Rohstoffe zu verwandeln. So könnten Kunststoffe zersetzt und in nutzbare Biomasse transformiert werden[6].
Biologisches Recycling von Kunststoff kann eine wertvolle Ergänzung in der Kreislaufwirtschaft sein. Zudem könnten noch unentdeckte Mikroorganismen und Biokatalysatoren künftig neue Wege eröffnen, Plastik effizient zu verwerten. Diese Methode darf jedoch nicht dazu führen, dass gebrauchtes Plastik achtlos in die Umwelt gelangt. Ziel ist es, Kunststoff im Kreislauf zu halten. Dass Mikroben, Pilze und Enzyme Kunststoff zersetzen und in wertvolle Bausteine umwandeln, bietet einen neuen Ansatz in der Materialrückführung – der auch hilft, bereits in der Umwelt befindlichen Plastikmüll zu reduzieren. Bio-Recycling macht dort Sinn, wo herkömmliche Recyclingmethoden an ihre Grenzen stoßen und Plastik bislang ungenutzt verloren geht.
Quelle: Initiative „Plastic is Fantastic“
[1] https://en.wikipedia.org/wiki/Ideonella_sakaiensis
[2] https://en.wikipedia.org/wiki/Parengyodontium_album
[3] https://www.nature.com/articles/s41557-025-01845-5
[4] https://en.wikipedia.org/wiki/Plastisphere
[5] https://www.wsl.ch/de/projekte/biologische-zersetzung-von-plastik-bei-niedrigen-temperaturen/
[6] https://recover-bbi.eu/project/
(Erschienen im EU-Recycling Magazin 01/2026, Seite 26, Foto: Initiative „Plastic is Fantastic“)